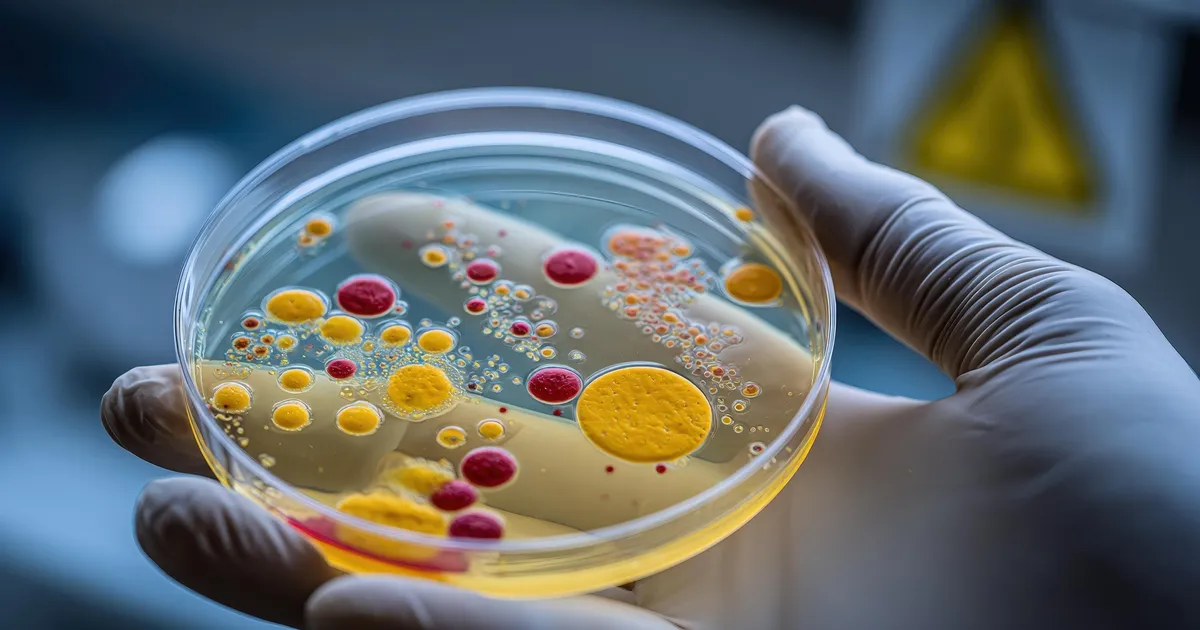
GLOBAALNE OHT ⟩ Ravimitele allumatud superbakterid levivad ohtliku kiirusega

UURING ⟩ Kolm toitu, mis võivad eluiga pikendada kuni kümne aasta võrra
Me kõik muretseme aeg-ajalt oma tervise pärast. Kuigi enamik teab, et toitumine mängib heaolus võtmerolli, võivad suured elustiilimuutused tunduda keerulised – eriti kiire elute...